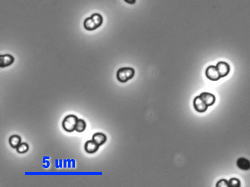

◆◇◆ ━━━━━━━━━━━━━━━━━━━━━━━━━━━ ◆◇◆
NBRCニュース No. 13(2012.2.1)
◆◇◆ ━━━━━━━━━━━━━━━━━━━━━━━━━━━ ◆◇◆
NBRCニュース第13号をお届けします。NBRCニュースも創刊から丸2年を迎え
ました。ご利用いただき、まことにありがとうございます。引き続き以下のホ
ームページで、今後掲載を希望される記事などについて、ご意見を募集してお
ります(2月29日まで)。簡単なアンケートですので、ご協力のほどよろしく
お願いいたします。
【アンケート】 http://www.nbrc.nite.go.jp/questionnaire.html
(等幅フォントでご覧ください)
======================================================================
内容
======================================================================
1.新たにご利用可能となった微生物株(2011年11月23日~2012年1月20日)
2.微生物あれこれ(10)
放射線耐性細菌Deinococcus属
3.微生物の保存法(7)
細菌の継代培養による保存
4.NITEが解析した微生物ゲノム(7)
インフルエンザウイルス解析について
5.カルタヘナ法-はじめての産業利用申請-(3)
経済産業省への申請手続きについて
6.2012年度日本農芸化学会大会シンポジウムのお知らせ
生物資源は誰のもの? ~名古屋議定書からわかること~
======================================================================
1.新たにご利用可能となった微生物株(2011年11月23日~2012年1月20日)
======================================================================
酵母 7件、糸状菌 10株、細菌 25株を新たに公開しました。
【新規公開株一覧】
https://www.nite.go.jp/nbrc/cultures/nbrc/new_strain/new_dna.html
======================================================================
2.微生物あれこれ(10)
放射線耐性細菌Deinococcus属 (森 浩二)
======================================================================
放射線に耐性を示す細菌として最も有名なのがDeinococcus属です。本属で
最も古くに分離された種はD. radioduransで、種名の“radiodurans”は“放
射線に抵抗を示す”という意味であり、この種がガンマ線により殺菌処理され
た肉の缶詰より分離されたことに由来します。もともとD. radioduransは、そ
の形態や生理性状から放線菌の一種として分類されていましたが、その後の16
S rRNA遺伝子等による系統分類学的解析から“Deinococcus-Thermus”門に属
するDeinococci綱Deinococcales目Deinococcaceae科の唯一の属に分類されて
います。Deinococcus属は好気性かつ中温性の細菌であり、赤や黄色のコロニ
ーを形成します。現在までに45種が報告されていますが、その分離源は、川の
水、空気中、根圏、活性汚泥、魚の腸管等々の一般的な環境から、ガンマ線照
射された食品、放射線で汚染された土壌、ラジウム温泉、砂漠、高山、成層圏
や南極などの少々過酷な環境まで様々です。これらの事実から、Deinococcus
属は自然界において常在菌であり、放射線耐性というその特異な性状により過
酷な環境下におかれても逞しく生存することが可能であると考えられます。
![]() Deinococcus radiodurans NBRC 15346T |
D. radioduransは大腸菌がた ちまち死滅してしまうようなガ ンマ線を照射されても、しぶと く生存することができます。 Deinococcus属の全ての種が放 射線に対して抵抗性を持ってい るようです。胞子などの休眠状 態になることによって放射線に 耐えているのではなく、優れた DNA修復機構によって放射線に 抵抗しています。生物が放射線 を大量に浴びた場合、生体情報 の根幹を成すDNAが高頻度で切 断され、その修復が追いつかな くなり、重篤な状態に陥ります。 |
しかし、Deinococcus属は、放射線によってDNAが重度に損傷しても、強力な DNA修復機構が発動し、元通りにDNAを繋げていくわけです。 酸素呼吸において生成してしまう活性酸素など、環境中には放射線以外にも DNAに損傷をもたらす様々な物質が存在します。このため、全ての生物はDNA修 復機構を持っていて、常に傷ついたDNAを修復しながら生きています。Deino- coccus属は、このDNA修復能力が生物の中で抜群に優秀であるようです。すな わち、Deinococcus属は、放射線に抵抗を示す細菌群と言うよりは、様々な極 限環境下でDNAが重度に損傷してしまう状況におかれたとしても生存すること が可能な細菌群であると言えます。近年、Deinococcus属のDNA修復機構につい て、少しずつ明らかになってきていますし、バイオテクノロジー分野への応用 も始まっています。 ====================================================================== 3.微生物の保存法(7) 細菌の継代培養による保存 (中川恭好) ====================================================================== 細菌は世代交代が早いため変異がおこりやすく、きわめて短期間で死滅する ものもありますので、菌株を入手したら直ちに保存することをお勧めします。 長期間の保存では凍結や乾燥保存が適していますが、短期間に頻繁に使用する 時には継代培養で維持した方が便利なこともあります。今回は、継代培養保存 の一般的な注意点と、継代培養保存の変法である軟寒天法を紹介いたします。 ◆ 継代培養保存の注意点 継代培養保存法では、菌株を定期的に新しい培地に植え継いで培養して保存 します。継代する時には、雑菌汚染や菌株の取り違いがおこる可能性がありま すので、これらには十分な注意が必要です。継代を繰り返すと、色素や生理活 性物質などの物質生産能や胞子形成能が低下したりすることもみられます。 細菌を継代培養で維持する場合は、栄養成分濃度が低い培地の方が、保存性 が良くなることが多いです。例えば、通常の培養に用いる培地の濃度を1/2程 度にして使用します。また、乳酸菌や酢酸菌などは、培地中に酸を生成し菌が 死滅します。このような菌については、酸を中和させるために培地に少量の沈 降性炭酸カルシウムを加えておくと生存期間を長くすることができます(NBRC ニュース第12号微生物の培養法 (6)参照)。 培養した菌は、一般的には5℃前後で冷蔵保存します。しかし、低温ではな く室温の方が生存期間が長くなる菌もあり、保存に適した温度は菌株によって 異なります。高温で培養する菌は、保存温度が低すぎると保存性が悪くなるこ とが多いようです。植え継ぎ間隔(生存期間)は、各菌株によって異なります ので、注意が必要です。 ◆ 軟寒天法(ソフトアガー法) 高層の軟寒天培地に穿刺培養したものを密栓して保存する方法で、保存中に 乾燥して菌が死滅することを防ぐと同時に、酸素供給を制限して菌の代謝活性 を下げることによって、保存期間を延長することが可能となります。大腸菌、 Bacillus、Pseudomonasなど様々の種類の細菌を1年以上保存できることが知ら れています。以下に手順を紹介します。 (1) 通常の培養に用いる培地の栄養分濃度を1/2、寒天濃度を約0.7%にした培 地を用意します。培地をスクリューキャップ付き試験管の半分くらいの高 さまで入れ、高層の軟寒天培地を作製します。 (2) 白金線あるいはディスポニードルを用いて、培地の2/3程度の深さまで突 き刺して菌を接種し、培養します。 (3) 生育したらキャップを固く閉めて密栓し、5~20℃で保存します。菌は培 養しすぎないようにして下さい。
![]() 軟寒天培地(全体) |
![]() 接種の様子 |
![]() 左:培養後、右:接種直後 |
====================================================================== 4.NITEが解析した微生物ゲノム(7) インフルエンザウイルス解析について (小口晃央) ====================================================================== NITEでは、これまでに蓄積してきたゲノム解析技術を国民生活の向上に役立 てるため、平成18年より国立感染症研究所との共同事業として、毎年流行する 季節性インフルエンザウイルスの流行株の正確な予測と薬剤耐性株や高リスク 株のモニタリングを目的としたヒトインフルエンザウイルスの遺伝子解析を実 施しています。 インフルエンザは国内だけでも毎年1,000万人規模が罹患し、肺炎等の合併 症による関連死亡者数は多い年には1万人を越えるとも推定されています。こ のように人類にとっては最も身近で、社会的だけでなく経済的にも大きな損失 をもたらしている病気です。 インフルエンザの予防にはワクチンが用いられますが、インフルエンザウイ ルスは突然変異の蓄積によって少しずつ抗原性(ワクチンとの適合性)を変化 させるため、毎年翌シーズンに流行するウイルスを正しく予測し、それに適合 するワクチン株を選定する必要があります。また、最近はウイルスそのものに 作用する数種類の抗ウイルス薬(タミフル、リレンザ等)が開発されています が、使用量の増加に伴う薬剤耐性株の出現が大きな問題となっています。NITE は、国内及び東アジア諸国の感染者から分離されたインフルエンザウイルス株 について、抗原性の違いや増殖に関与する遺伝子の塩基配列を解析しており( 累計4,500株以上)、これらのデータは、世界保健機関(WHO)を中心とする世 界的なネットワークの中で、ワクチン株の選定や薬剤耐性ウイルスの監視に利 用されています。2009年のパンデミック(新型インフルエンザの大流行)時に は、国立感染症研究所との連携のもと、新型インフルエンザウイルス分離株の 全遺伝子塩基配列解析などを迅速に行いました。 解析データが蓄積すれば、流行株の予測精度が向上することが期待され、有 効なワクチン株の選定が行われれば、インフルエンザによる病状の悪化や死亡 のリスクが軽減されます。また、薬剤耐性株の塩基配列や流行動向を明らかに することにより、より効果的な薬剤の備蓄、投薬、監視体制の構築、耐性の出 にくい薬剤の開発等に役立てることができることも期待されています。 【詳細】 https://www.nite.go.jp/nbrc/genome/project/influenza/index.html ====================================================================== 5.カルタヘナ法-はじめての産業利用申請-(3) 経済産業省への申請手続きについて (藤田克利) ====================================================================== 今回は産業利用(第二種使用)のために経済産業省に提出する大臣確認の申 請書の作成と、申請の流れについて説明します。大臣確認の必要性については NBRCニュース第11、12号をご覧ください。拡散防止措置や宿主の種類によって 大臣確認申請の流れが異なり、産業利用の拡散防止措置はGILSP(Good Industrial Large Scale Practice)とカテゴリー1など、宿主は微生物、ウ イルス、動物及び植物に分かれます。以前は全ての申請が定期開催される産業 構造審議会の審議を経て大臣確認されていましたが、昨年6月から拡散防止措 置がGILSPの場合は、随時NITEでの事前審査を行うことになりました。ここで は宿主が微生物で、拡散防止措置がGILSPの場合の申請手続きを説明いたしま す。 (1) 申請書の作成 経済産業省のホームページより申請書の様式(第二種使用等拡散防止措置確 認申請書)を入手します。様式は3種類あり、微生物を宿主とする場合は様式 第一を使用します。同時に申請書作成のマニュアル「カルタヘナ法に基づく産 業上の使用等に係る第二種使用等(経済産業省所管分野)拡散防止措置の確認 申請手続きに係る資料の作成・提出等について」と最新のGILSPリスト「遺伝 子組換え生物等の第二種使用等のうち産業上の使用等に当たって執るべき拡散 防止措置等を定める省令別表第一号の規定に基づき経済産業大臣が定める GILSP遺伝子組換え微生物」も同時に入手します。 マニュアルに従って書類を作成します。経済産業省への提出書類は白黒印刷 となっていますので、カラーは使用しないでください。また、宿主や挿入遺伝 子の由来生物の病原性(BSL)、GILSPリストの掲載の有無は、最新版のリスト やデータを参照してください。ここが申請書類で一番修正の多い箇所となって います。GILSPリストについては、次回説明いたします。 (2) 事前確認 作成した申請書類をNITEバイオ安全審査室に郵送またはEメールでお送りく ださい。申請書類の内容に不足等がないかを事前に確認します。この段階で何 度か修正をお願いすることがあります。 (3) 事前審査 事前確認が終わると事前審査に移ります。事前審査は、経済産業省が昨年6 月に公開したチェックリストに基づいてNITEで行います。事前審査開始から2 週間以内に事前審査結果をEメールでお知らせします。別途事前審査結果通知 書を郵送しますので、経済産業省への本申請時に添付して下さい。 (4) 本審査 本審査は経済産業省が行います。事前審査結果通知書が添付されている場合 は、申請書の受付から2週間以内に本審査の結果が通知され、大臣確認書が送 付されます。通知後は、産業利用に着手できます。 宿主や挿入遺伝子に病原性がある場合や、宿主がウイルス・動物・植物の場 合は上述とは流れが異なります。これについては、別の機会で紹介できればと 思います。また、GILSP区分以外でも事前相談と事前確認は受けられます。ご 不明の点がございましたら、下記連絡先までお問い合わせください。 【大臣確認申請書およびマニュアルの入手先(経済産業省)】 http://www.meti.go.jp/policy/mono_info_service/mono/bio/ cartagena/anzen-shinsa2.html 【事前相談、事前審査の宛先(NITEバイオ安全審査室)】 nite-cartagena@nite.go.jp ====================================================================== 6.2012年度日本農芸化学会大会シンポジウムのお知らせ 生物資源は誰のもの? ~名古屋議定書からわかること~ ====================================================================== 2010年10月に名古屋で開催された生物多様性条約第10回締約国会議において 遺伝資源へのアクセスとその利用から生じる利益の公平かつ衡平な配分に関す る議定書「名古屋議定書」が採択されました。「名古屋議定書」は生物遺伝資 源の利用者にとっては極めて重要なものであり、その理解なくして生物遺伝資 源を利用することは、無用な国際紛争の種にもなりかねません。本シンポジウ ムでは上智大学の磯崎博司教授に法律的見地から議定書に関して解説いただく とともに、各企業、研究機関等が名古屋議定書をどのように捉え、海外生物資 源を用いた応用研究を展開していくのか、名古屋議定書を好機と捉えた基礎研 究から応用研究に関する話題を提供します。 日時:2012年3月25日(日) 13:30~16:30 場所:京都女子大学 http://www.kyoto-wu.ac.jp/ 講演内容:(1) 名古屋議定書の概略とその影響 磯崎博司 氏 上智大学大学院 (2) 二国間協力による海外生物資源へのアクセス 鶴海泰久 独・製品評価技術基盤機構 (3) ベトナムにおける発酵食品からの微生物の探索 加戸久生 氏 サッポロビール株式会社 (4) 醗酵創薬における熱帯微生物の活用について 村松秀行 氏 アステラスリサーチテクノロジー株式会社 世話人:乙黒美彩、鶴海泰久 申込先:日本農芸化学会大会ホームページより参加登録が必要です。 http://www.jsbba.or.jp/2012/ ====================================================================== 編集後記 ====================================================================== 寒くなると、なぜかチョコレートを食べたくなります。チョコレートをおい しく作るためには、テンパリングという作業が必要になるそうです。テンパリ ングはチョコレートをまず50℃の湯煎にかけ、その後28℃まで下げ、再度湯煎 にかけ32℃まで上げるという作業です。PCRを思い出すのは自分だけでしょう か?(テンパリングはサイクルは回しませんが)。(NK) ◆◇◆ ━━━━━━━━━━━━━━━━━━━━━━━━━━━ ◆◇◆ ・NBRCニュースは配信登録いただいたメールアドレスにお送りしております。 万が一間違えて配信されておりましたら、お手数ですが、下記のアドレスに ご連絡ください。 ・ご質問、転載のご要望など、NBRCニュースについてのお問い合わせは、下記 のアドレスにご連絡ください。 ・掲載内容は予告なく変更することがございます。掲載内容を許可なく複製・ 転載されることを禁止します。 ・偶数月の1日(休日の場合はその前後)に配信しております。第14号は3月30 日に配信予定です。 編集・発行 独立行政法人製品評価技術基盤機構(NITE)バイオテクノロジーセンター NBRCニュース編集局(nbrcnews@nite.go.jp) ◆◇◆ ━━━━━━━━━━━━━━━━━━━━━━━━━━━ ◆◇◆